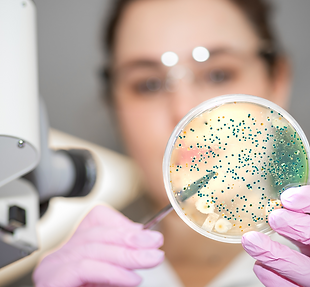
9.png

top of page

Test MicroBIOME

Descripción del test
Test MicroBIOME hace un análisis metagenómico de todos los genes de las bacterias que residen en el intestino. Realizando un estudio profundo, objetivo, dando información detallada sobre microorganismos y su impacto en la salud del paciente.
​
Se realiza para:
-
Determinar la salud digestiva
-
Determinar enfermedades metabólicas
-
Determinar enfermedades neurodegenerativas.
-
Analiza hongos y parásitos de gran importancia en la salud.
-
Aporta recomendaciones nutricionales personalizadas para alcanzar un equilibrio adecuado.
​
¿Qué se analiza?
Todo el material genético de la muestra
Detecta todas las especies
<0,01%
Alta resolución y cobertura, de todos los microorganismos
Bacterias arqueas Hongos
Protistas.
Tipo de Tests
bottom of page